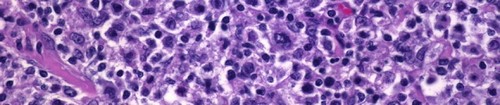
lymphomaboy's profile picture. 37 years old. Diagnosed NHL 11/08, RCVP, RCHOP, GEM-P, PMITCEBOM.  Stem cell transplant 12/09. Relapse 17/09/10 PCEGemBOM started 02/10/10. Remission again!

CancerWebMED
@CancerWebMED
CancerWebMED is the most up-to-date cancer news reporting site. We get our news directly from their publication journals as well as the general press.
You might like
It is time to say goodbye to CancerWebMED! We joined forces and started a new cancer information site.
Immune system changes may drive aggressiveness of recurrent tumors cancerwebmed.com/index.php/brea…
Research sheds new light on mechanisms of T-ALL, a form of leukemia that primarily affects children cancerwebmed.com/index.php/brea…
Watson seeks approval of generic version of cancer drug Velcade cancerwebmed.com/index.php/canc…
Study Hints at Potential Increased Risk of Cancer Among 9/11 Rescue Workers cancerwebmed.com/index.php/canc…
Study links milk-producing protein to aggressive breast cancer cancerwebmed.com/index.php/canc…
Study: Cancer drug substitute linked to higher rate of relapse cancerwebmed.com/index.php/canc…
Elwood V. Jensen, Pioneer in Breast Cancer Treatment, Dies at 92 cancerwebmed.com/index.php/canc…
Cancer screening rates fall in U.S. over last decade, study finds cancerwebmed.com/index.php/canc…
Observation as Good as Surgery for Some Men with Prostate Cancer cancerwebmed.com/index.php/clin…
Exercise, Behavioral Therapy Reduce Menopausal Symptoms Caused by Breast Cancer Treatment cancerwebmed.com/index.php/clin…
Newly Identified Gene Mutations May Prompt 10% Of Ovarian Cancers http://goo.gl/fb/mbjMB
Etaracizumab (Abegrin) does not add significant benefit to dacarbazine in patients with stage… http://goo.gl/fb/M3xN
Serum amyloid A : A new biomarker for endometrial cancer http://bit.ly/5tD1ar
United States Trends
- 1. #WWERaw N/A
- 2. Isaiah Stewart N/A
- 3. Miles Bridges N/A
- 4. AJ Lee N/A
- 5. Duren N/A
- 6. Becky N/A
- 7. Moussa N/A
- 8. Tozawa N/A
- 9. Megyn Kelly N/A
- 10. David Njoku N/A
- 11. #RawOnNetflix N/A
- 12. Otis N/A
- 13. Alpha Academy N/A
- 14. Bediako N/A
- 15. Paul Reed N/A
- 16. The Usos N/A
- 17. Lyra N/A
- 18. Hornets Pistons N/A
- 19. iTunes N/A
- 20. Mikel Brown N/A
You might like
-
 The Cancer Letter
The Cancer Letter
@TheCancerLetter -
 Annals of Oncology
Annals of Oncology
@Annals_Oncology -
 ACS Journal Cancer
ACS Journal Cancer
@JournalCancer -
 CancerNetwork®
CancerNetwork®
@CancerNetwrk -
 JNCI
JNCI
@JNCI_Now -
 ecancer
ecancer
@ecancer -
 Bermuda Cancer and Health Centre
Bermuda Cancer and Health Centre
@BdaCancerHealth -
 HemOnc Today
HemOnc Today
@HemOncToday -
 Fight Colorectal Cancer
Fight Colorectal Cancer
@FightCRC -
 UNC Lineberger
UNC Lineberger
@UNC_Lineberger -
Senology
@Senology -
 Ray DuBois, MD, PhD
Ray DuBois, MD, PhD
@Rndubois -
 ONCOAMERICA/RISMED
ONCOAMERICA/RISMED
@oncoamerica
Something went wrong.
Something went wrong.